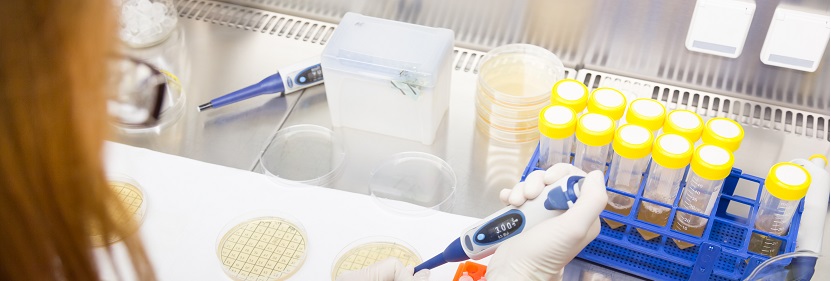
聚碳酸酯樹脂檢測

懸浮填料檢測
健明迪檢測提供的懸浮填料檢測,檢測項目 直徑、比表面積、堆積個數、堆積密度、使用壽命、顆粒外觀、密度、熔體質量,檢測標準 HJ/T246-2006環境保護產品技術要求懸浮填料 GB/T191包,具有CMA,CNAS資質。

懸浮填料檢測 檢測項目
直徑、比表面積、堆積個數、堆積密度、使用壽命、顆粒外觀、密度、熔體質量流動速率MFR、拉伸屈服應力、拉伸斷裂標稱應變、簡支梁缺口沖擊強度、環境應力開裂時間、彎曲模量、氧化誘導時間、拉伸斷裂應變、魚眼、條紋、霧度、熔脹比、相對電容率、拉伸斷裂應力、清潔度、熔體流動速率、粉末灰分、拉伸屈服強度、斷裂伸長率、簡支梁沖擊強度、懸臂梁沖擊強度、環境應力開裂、沖擊脆化溫度、等規指數、軟化點、負荷變形溫度、模塑收縮率、洛氏硬度、外觀、酸值、粘度、凝膠時間、固體含量、巴柯爾硬度、熱變形溫度、彎曲強度、彎曲彈性模量、破壞伸長率、耐燃性、耐堿性、等等
懸浮填料檢測 檢測介紹
懸浮填料指使用時在被處理水體中處于懸浮、流化狀態的填料。整體呈環形的懸浮填料,稱為環狀懸浮填料;整體呈空心柱狀的懸浮填料,稱為柱狀懸浮填料;整體呈球形的懸浮填料,稱為球形懸浮填料;由塑料注塑成籠架,內裝絲狀、條狀材料等組合式的懸浮填料,稱為組合懸浮填料。
懸浮填料檢測 檢測標準
HJ/T 246-2006環境保護產品技術要求 懸浮填料
GB/T 191包裝儲運圖示標志
GB/T6388運輸包裝收發貨標志
GB/T8237玻璃纖維增強塑料(玻璃鋼)用液體不飽和聚酯樹脂
GB11115低密度聚乙烯樹脂
GB 11116高密度聚乙烯樹脂
GB12670聚丙烯樹脂
HG/T21556.3聚丙烯鮑爾環填料
GB/T 191包裝儲運圖示標志
GB/T6388運輸包裝收發貨標志
GB/T8237玻璃纖維增強塑料(玻璃鋼)用液體不飽和聚酯樹脂
GB11115低密度聚乙烯樹脂
GB 11116高密度聚乙烯樹脂
GB12670聚丙烯樹脂
HG/T21556.3聚丙烯鮑爾環填料